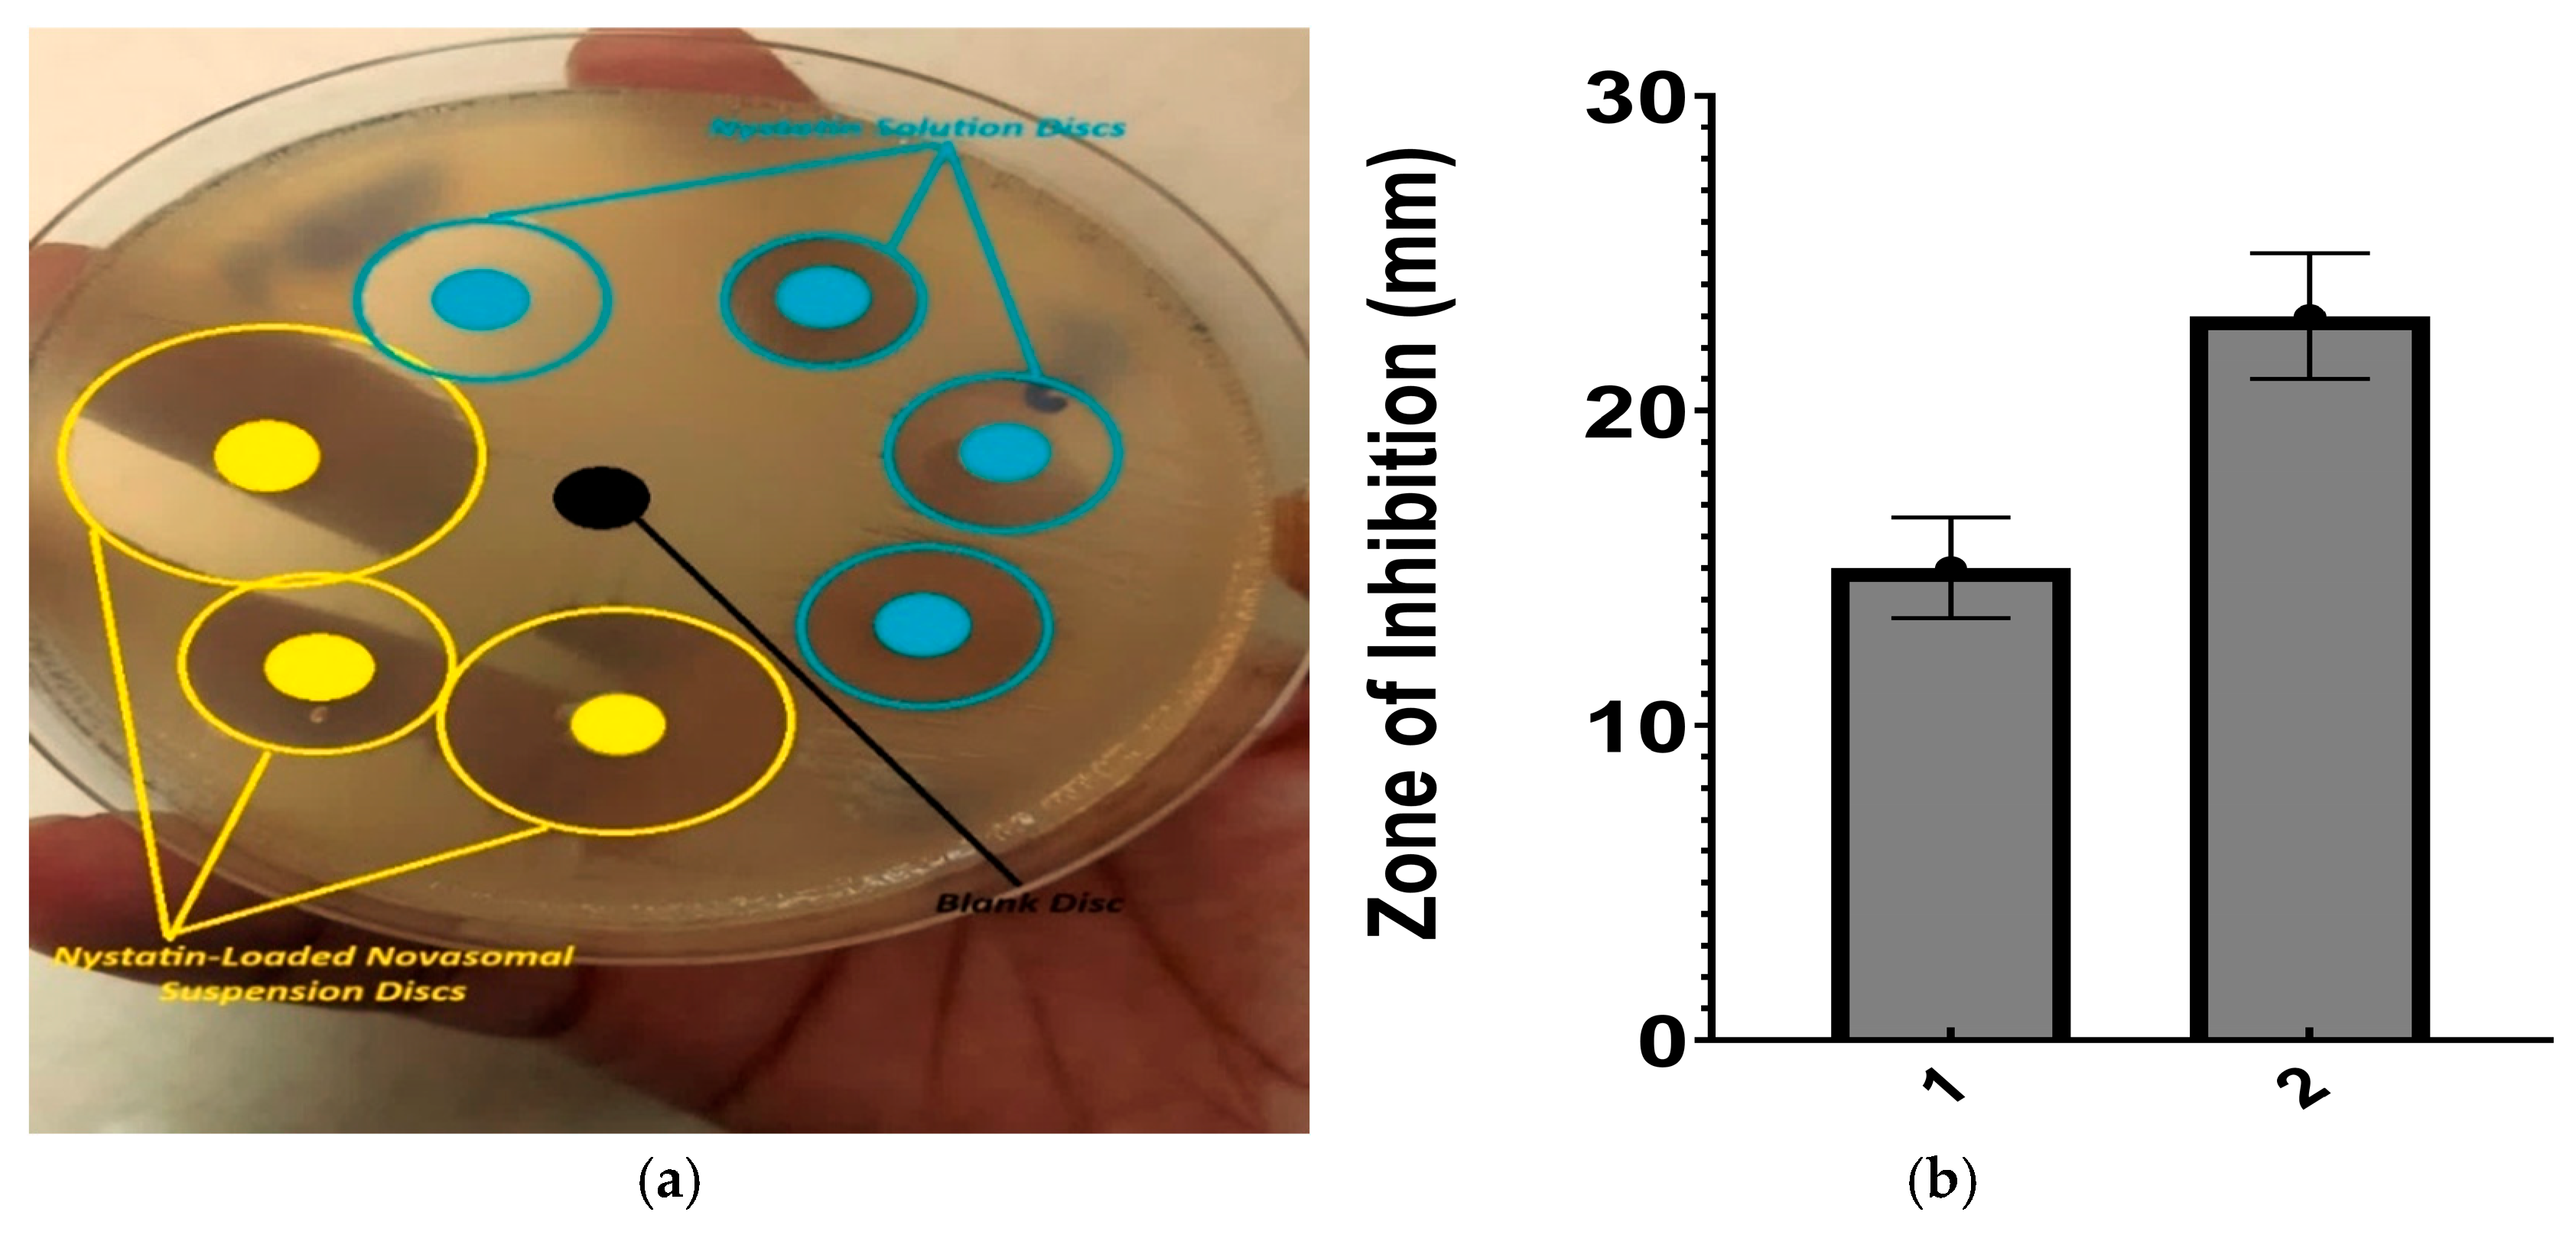
Gels 11 00774 g007

Development and Evaluation of Nystatin-Loaded Novasomal Gel for the Treatment of Candida albicans Infection: In Vitro Microbiological and Skin Compatibility Study
Abstract
1. Introduction
2. Results and Discussion
2.1. Results
2.1.1. Formulation Physical Appearance
2.1.2. Entrapment Efficiency and pH Measurement
2.1.3. Viscosity and Rheological Properties
2.1.4. Zeta Potential, PDI, and Particle Size
2.1.5. Thermal Analysis
2.1.6. FTIR
2.1.7. SEM
2.1.8. XRD
2.1.9. Stability Studies
2.1.10. Standard Calibration Curve
2.1.11. In Vitro Drug Release
2.1.12. Release Kinetics Studies
2.1.13. Antifungal Activity of Nystatin-Loaded Novasomes
- (a)
- Agar wall diffusion method
- (b)
- Minimum inhibitory concentration
2.1.14. In Vivo Skin Irritation
2.2. Discussion
3. Conclusions
4. Materials and Methods
4.1. Materials
4.2. Preparation of Phosphate Buffer Solution (pH: 7.4)
4.3. Preparation of Novasomes and Novasomal Gel
4.4. Evaluation of Nystatin-Loaded Novasomes Gel
4.4.1. pH Measurements
4.4.2. Viscosity and Rheological Evaluation
4.4.3. Entrapment Efficiency
4.4.4. Zeta Potential, PDI, and Particle Size
4.4.5. Thermal Analysis
4.4.6. Fourier Transform Infrared Spectroscopy (FTIR)
4.4.7. Scanning Electron Microscopy (SEM)
4.4.8. XRD Analysis
4.4.9. Standard Curve for Drug Quantification
4.4.10. In Vitro Drug Release and Release Kinetics
4.4.11. Antifungal Activity of Nystatin-Loaded Novasomes
- (a)
- Agar well diffusion method
- (b)
- Minimum Inhibitory Concentration (MIC)
4.4.12. In Vivo Skin Irritation
4.4.13. Statistical Analysis
Supplementary Materials
Author Contributions
Funding
Institutional Review Board Statement
Informed Consent Statement
Data Availability Statement
Acknowledgments
Conflicts of Interest
References
- Tanner, T.; Marks, R. Delivering Drugs by the Transdermal Route: Review and Comment. Skin Res. Technol. 2008, 14, 249–260. [Google Scholar] [CrossRef]
- Denning, D.W. Global Incidence and Mortality of Severe Fungal Disease. Lancet Infect. Dis. 2024, 24, e428–e438. [Google Scholar] [CrossRef]
- Srikanth, K.; Gupta, V.R.M.; Devanna, N. Formulation and Evaluation of Nystatin Loaded Niosomes. Int. J. Pharm. Sci. Res. 2013, 4, 2015. [Google Scholar]
- Yamasaki, M.; Tamura, N.; Nakamura, K.; Sasaki, N.; Murakami, M.; Rajapakshage, W.; Kumara, B.; Tamura, Y.; Lim, S.Y.; Ohta, H.; et al. Effects and Mechanisms of Action of Polyene Macrolide Antibiotic Nystatin on Babesia gibsoni In Vitro. J. Parasitol. 2011, 97, 1190–1192. [Google Scholar] [CrossRef]
- Dos Santos, A.G.; Marquês, J.T.; Carreira, A.C.; Castro, I.R.; Viana, A.S.; Mingeot-Leclercq, M.P.; de Almeida, R.F.M.; Silva, L.C. The Molecular Mechanism of Nystatin Action Is Dependent on the Membrane Biophysical Properties and Lipid Composition. Phys. Chem. Chem. Phys. 2017, 19, 30078–30088. [Google Scholar] [CrossRef] [PubMed]
- Singh, A.; Malviya, R.; Sharma, P.K. Novasome—A Breakthrough in Pharmaceutical Technology: A Review Article. Adv. Biol. Res. 2011, 5, 184–189. [Google Scholar]
- Mustafa, M.A.; Rasheed, N.; Ayesha, M.; ul Ain, Q.; Mughal, M.; Fahad, M.; Shakir, H.; Ijaz, A.; Tahir, M.A.; Muhammad, M. Novasomes: A Versatile Drug Delivery System for Enhanced Therapeutic Efficacy. J. Young Pharm. 2025, 17, 36–45. [Google Scholar] [CrossRef]
- Theochari, I.; Xenakis, A.; Papadimitriou, V. Nanocarriers for Effective Drug Delivery. In Smart Nanocontainers; Elsevier: Amsterdam, The Netherlands, 2020; pp. 315–341. [Google Scholar]
- Farooq, M.; Usman, F.; Zaib, S.; Shah, H.S.; Jamil, Q.A.; Sheikh, F.A.; Khan, A.; Rabea, S.; Hagras, S.A.; Batiha, G.E.-S. Fabrication and Evaluation of Voriconazole Loaded Transethosomal Gel for Enhanced Antifungal and Antileishmanial Activity. Molecules 2022, 27, 3347. [Google Scholar] [CrossRef] [PubMed]
- Imam, S.S.; Gilani, S.J.; Zafar, A.; Jumah, M.N.B.; Alshehri, S. Formulation of Miconazole-Loaded Chitosan–Carbopol Vesicular Gel: Optimization to In Vitro Characterization, Irritation, and Antifungal Assessment. Pharmaceutics 2023, 15, 581. [Google Scholar] [CrossRef]
- Abdelbari, M.A.; El-Gazar, A.A.; Abdelbary, A.A.; Elshafeey, A.H.; Mosallam, S. Investigating the Potential of Novasomes in Improving the Trans-Tympanic Delivery of Niflumic Acid for Effective Treatment of Acute Otitis Media. J. Drug Deliv. Sci. Technol. 2024, 98, 105912. [Google Scholar] [CrossRef]
- Chawalke, P.; Zafar, A.; Binshaya, A.S.; Shmrany, H.A.; Hazazi, A.; Abalkhail, A.; Khan, F.R.; Satpute, K.; Syed, S.M. Topical Miconazole Nanogel: In Vitro Characterization, In Vivo Skin Irritation, and Enhanced Antifungal Efficacy. Drug Dev. Res. 2025, 86, e70106. [Google Scholar] [CrossRef]
- Hani, U.; Paramshetti, S.; Angolkar, M.; Alqathanin, W.K.; Alghaseb, R.S.; Al Asmari, S.M.; Alsaab, A.A.; Fatima, F.; Osmani, R.A.M.; Gundawar, R. Cyclodextrin-Nanosponge-Loaded Cyclo-Oxygenase-2 Inhibitor-Based Topical Gel for Treatment of Psoriatic Arthritis: Formulation Design, Development, and In Vitro Evaluations. Pharmaceuticals 2024, 17, 1598. [Google Scholar] [CrossRef]
- Abd-Elal, R.M.; Shamma, R.N.; Rashed, H.M.; Bendas, E.R. Trans-Nasal Zolmitriptan Novasomes: In Vitro Preparation, Optimization and In Vivo Evaluation of Brain Targeting Efficiency. Drug Deliv. 2016, 23, 3374–3386. [Google Scholar] [CrossRef]
- Fatima, I.; Rasul, A.; Shah, S.; Saadullah, M.; Islam, N.; Khames, A.; Salawi, A.; Ahmed, M.M.; Almoshari, Y.; Abbas, G. Novasomes as Nano-Vesicular Carriers to Enhance Topical Delivery of Fluconazole: A New Approach to Treat Fungal Infections. Molecules 2022, 27, 2936. [Google Scholar] [CrossRef]
- Benavent Núñez, C.; Torrado Salmerón, C.F.; Torrado Durán, S. Development of a Solid Dispersion of Nystatin with Maltodextrin as a Carrier Agent: Improvements in Antifungal Efficacy against Candida spp. Biofilm Infections. Pharmaceuticals 2021, 14, 397. [Google Scholar] [CrossRef] [PubMed]
- Jacob, S.; Abdullahi, J.O.; Usman, S.; Boddu, S.H.S.; Khan, S.N.; Saad, M.A.; Nair, A.B. Preparation and Evaluation of Tadalafil-Loaded Nanoemulgel for Transdermal Delivery in Cold-Induced Vasoconstriction: A Potential Therapy for Raynaud’s Phenomenon. Pharmaceutics 2025, 17, 596. [Google Scholar]
- Ahmed, S.; Farag, M.M.; Attia, H.; Balkhi, B.; Adel, I.M.; Nemr, A.A. Exploring the Potential of Antifungal-Loaded Proniosomes to Consolidate Corneal Permeation in Fungal Keratitis: A Comprehensive Investigation from Laboratory Characterization to Microbiological Evaluation. Int. J. Pharm. X 2025, 9, 100322. [Google Scholar] [CrossRef]
- Abdelkader, H.; El-Wahab, A.A.; El-Gendy, A.O.; Abou-Taleb, H.A. Formulation and Optimization of Lipid- and Poloxamer-Tagged Niosomes for Dermal Delivery of Terbinafine: Preparation, Evaluation, and In Vitro Antifungal Activity. Pharm. Dev. Technol. 2023, 28, 803–810. [Google Scholar] [CrossRef] [PubMed]
- Belsito, D.V.; Hill, R.A.; Klaassen, C.D.; Liebler, D.C.; Marks, J.G., Jr.; Shank, R.C.; Slaga, T.J.; Snyder, P.W. Safety Assessment of Keratin and Keratin-Derived Ingredients as Used in Cosmetics. Int. J. Toxicol. 2016, 35 (Suppl. S2), 1S–10S. [Google Scholar]
- Negi, P.; Aggarwal, M.; Sharma, G.; Rathore, C.; Sharma, G.; Singh, B.; Katare, O. Niosome-Based Hydrogel of Resveratrol for Topical Applications: An Effective Therapy for Pain-Related Disorders. Biomed. Pharmacother. 2017, 88, 480–487. [Google Scholar]
- Shilakari Asthana, G.; Asthana, A.; Singh, D.; Sharma, P.K. Etodolac Containing Topical Niosomal Gel: Formulation Development and Evaluation. J. Drug Deliv. 2016, 2016, 9324567. [Google Scholar] [CrossRef]
- Yeo, E.; Yew Chieng, C.J.; Choudhury, H.; Pandey, M.; Gorain, B. Tocotrienols-Rich Naringenin Nanoemulgel for the Management of Diabetic Wound: Fabrication, Characterization and Comparative In Vitro Evaluations. Curr. Res. Pharmacol. Drug Discov. 2021, 2, 100019. [Google Scholar] [CrossRef]
- Postoy, V.; Kukhtenko, H.; Vyshnevska, L.; Gladukh, Y.V.; Semchenko, K. Study of Rheological Behaviour of Hydroxyethyl Cellulose Gels in the Development of the Composition and Technology of the Medicine with Anti-Inflammatory Activity. Pharmacia 2019, 66, 25–30. [Google Scholar] [CrossRef]
- Revankar, A.A.; Patil, A.S.; Karishetti, R.; Chougule, K.R.; Patil, P.; Salokhe, A. Enhanced Bioavailability of Quercetin-Loaded Niosomal In Situ Gel for the Management of Parkinson’s Disease. Front. Pharmacol. 2025, 15, 1519649. [Google Scholar] [CrossRef] [PubMed]
- Ward, K.R.; Matejtschuk, P. Characterization of Formulations for Freeze-Drying. In Lyophilization of Pharmaceuticals and Biologicals: New Technologies and Approaches; Springer: Cham, Switzerland, 2018; pp. 1–32. [Google Scholar]
- Robinson, H.; Molendijk, J.; Shah, A.K.; Rahman, T.; Anderson, G.J.; Hill, M.M. Rapid Assessment of Lipidomics Sample Purity and Quantity Using Fourier-Transform Infrared Spectroscopy. Biomolecules 2022, 12, 1265. [Google Scholar] [CrossRef] [PubMed]
- El-Ridy, M.S.; Yehia, S.A.; Mohsen, A.M.; El-Awdan, S.A.; Darwish, A.B. Formulation of Niosomal Gel for Enhanced Transdermal Lornoxicam Delivery: In Vitro and In Vivo Evaluation. Curr. Drug Deliv. 2018, 15, 122–133. [Google Scholar] [CrossRef] [PubMed]
- Gulshan, S.; Shah, S.; Shah, P.A.; Irfan, M.; Saadullah, M.; Abbas, G.; Hanif, M.; Rasul, A.; Ahmad, N.; Mahmood, A. Development and Pharmacokinetic Evaluation of Novasomes for the Trans-Nasal Delivery of Fluvoxamine Using Arachidonic Acid–Carboxymethyl Chitosan Conjugate. Pharmaceutics 2023, 15, 2259. [Google Scholar] [CrossRef]
- Sulastri, E.; Rahma, M.N.; Herdiana, Y.; Elamin, K.M.; Mohammed, A.F.A.; Mahmoud, S.A.; Wathoni, N. Enhancing Antifungal Efficacy and Stability of Nystatin Liposomes through Chitosan and Alginate Layer-by-Layer Coating: In Vitro Studies Against Candida albicans. Int. J. Nanomed. 2025, 20, 10739–10750. [Google Scholar] [CrossRef]
- Bidaud, A.-L.; Schwarz, P.; Herbreteau, G.; Dannaoui, E. Techniques for the Assessment of In Vitro and In Vivo Antifungal Combinations. J. Fungi 2021, 7, 113. [Google Scholar] [CrossRef]
- Vieira-da-Silva, B.; Castanho, M.A. Resazurin Reduction-Based Assays Revisited: Guidelines for Accurate Reporting of Relative Differences on Metabolic Status. Molecules 2023, 28, 2283. [Google Scholar] [CrossRef]
- Verderio, P.; Lecchi, M.; Ciniselli, C.M.; Shishmani, B.; Apolone, G.; Manenti, G. 3Rs Principle and Legislative Decrees to Achieve High Standard of Animal Research. Animals 2023, 13, 277. [Google Scholar] [CrossRef] [PubMed]
- Waman, R.; Gupta, R.; Jain, S.K.; Vengurlekar, S. In Vivo Acute Dermal Irritation Study of Desonide–Curcumin Niosomal Gel: An Experimental Approach. J. Neonatal Surg. 2025, 14, 7190–7198. [Google Scholar]

| Formulation | Entrapment Efficiency (%) | pH (± SD) | Viscosity (cP) | Storage Modulus G′ (Pa) | Loss Modulus G″ (Pa) |
|---|---|---|---|---|---|
| F1 | 76.00 ± 1.20 | 5.71 ± 0.05 | 3900 ± 110 | 172 ± 7 | 28 ± 2.0 |
| F2 | 70.00 ± 0.90 | 6.01 ± 0.04 | 4050 ± 120 | 180 ± 8 | 30 ± 2.2 |
| F3 | 78.00 ± 1.10 | 6.36 ± 0.03 | 4150 ± 115 | 190 ± 8 | 31 ± 2.3 |
| F4 | 69.00 ± 1.30 | 5.99 ± 0.02 | 4000 ± 108 | 178 ± 7 | 29 ± 2.1 |
| F5 | 71.00 ± 1.00 | 6.65 ± 0.06 | 4200 ± 115 | 185 ± 8 | 32 ± 2.1 |
| F6 | 79.00 ± 1.40 | 6.99 ± 0.02 | 4380 ± 98 | 198 ± 7 | 36 ± 2.4 |
| F7 | 80.00 ± 1.50 | 6.98 ± 0.03 | 4510 ± 105 | 210 ± 9 | 39 ± 2.2 |
| F8 | 74.00 ± 1.00 | 6.51 ± 0.04 | 4300 ± 112 | 193 ± 8 | 34 ± 2.3 |
| F9 | 77.00 ± 1.20 | 6.59 ± 0.03 | 4400 ± 109 | 202 ± 8 | 35 ± 2.2 |
| Formulation | ZP (mV) | PS (nm) | PDI |
|---|---|---|---|
| F1 | −35.50 ± 5.0 | 8836 ± 36.9 | 0.26 ± 0.015 |
| F2 | −39.14 ± 6.6 | 9570 ± 41.2 | 0.29 ± 0.010 |
| F3 | −51.72 ± 3.2 | 6492 ± 33.7 | 0.20 ± 0.012 |
| F4 | −45.35 ± 1.2 | 4991 ± 41.6 | 0.13 ± 0.009 |
| F5 | −79.10 ± 4.8 | 7734 ± 29.4 | 0.08 ± 0.005 |
| F6 | −75.93 ± 8.1 | 4725 ± 23.1 | 0.02 ± 0.003 |
| F7 | −70.44 ± 2.9 | 4143 ± 37.8 | 0.09 ± 0.007 |
| F8 | −77.26 ± 5.6 | 5139 ± 46.3 | 0.05 ± 0.002 |
| F9 | −67.48 ± 9.2 | 6122 ± 35.1 | 0.01 ± 0.006 |
| Parameter | Time Point | Room Temp (25 °C) | Refrigerated (4 °C) |
|---|---|---|---|
| pH | Day 0 | 6.85 ± 0.03 | 6.85 ± 0.05 |
| Day 15 | 6.83 ± 0.02 | 6.84 ± 0.09 | |
| Day 30 | 6.89 ± 0.07 | 6.83 ± 0.01 | |
| Viscosity (cP) | Day 0 | 4320 ± 105 | 4320 ± 109 |
| Day 15 | 4310 ± 98 | 4325 ± 100 | |
| Day 30 | 4295 ± 102 | 4312 ± 95 | |
| Entrapment Efficiency (%) | Day 0 | 80.7 ± 1.2 | 80.1 ± 1.7 |
| Day 15 | 79.1 ± 1.4 | 80.9 ± 1.3 | |
| Day 30 | 79.4 ± 1.6 | 79.7 ± 1.5 | |
| Physical Appearance | Day 0 | No change | No change |
| Day 15 | No change | No change | |
| Day 30 | No change | No change |
| Formulation | Zero-Order (K0, %·h−1) | R2 | First-Order (K1, h−1) | R2 | Higuchi (K_H, %·h−1/2) | R2 | Korsmeyer– Peppas (K_KP, %·h−n) | n |
|---|---|---|---|---|---|---|---|---|
| F1 | 13.526 | 0.976 | 0.272 | 0.9437 | 30.821 | 0.6759 | 16.183 | 0.73 |
| F2 | 13.995 | 0.9243 | 0.275 | 0.9587 | 29.251 | 0.8097 | 20.577 | 0.853 |
| F3 | 12.857 | 0.9798 | 0.196 | 0.9845 | 31.253 | 0.7834 | 15.873 | 0.814 |
| F4 | 12.451 | 0.9643 | 0.209 | 0.9476 | 27.36 | 0.8789 | 18.936 | 0.76 |
| F5 | 13.321 | 0.9721 | 0.215 | 0.9572 | 28.014 | 0.6596 | 16.389 | 0.89 |
| F6 | 9.177 | 0.9876 | 0.154 | 0.9618 | 24.876 | 0.8548 | 11.237 | 0.838 |
| F7 | 8.451 | 0.9923 | 0.139 | 0.9575 | 22.343 | 0.8739 | 10.863 | 0.86 |
| F8 | 11.535 | 0.9764 | 0.127 | 0.9761 | 21.065 | 0.9714 | 16.803 | 0.818 |
| F9 | 10.886 | 0.9621 | 0.139 | 0.9468 | 25.315 | 0.9729 | 15.855 | 0.743 |
| Table | Mean Erythema ± SD | Mean Edema ± SD | Mean Combined ± SD |
|---|---|---|---|
| 24 | 0.33 ± 0.58 | 0.00 ± 0.00 | 0.33 ± 0.58 |
| 48 | 0.33 ± 0.58 | 0.00 ± 0.00 | 0.33 ± 0.58 |
| 72 | 0.00 ± 0.00 | 0.00 ± 0.00 | 0.00 ± 0.00 |
| Ingredients | F1 | F2 | F3 | F4 | F5 | F6 | F7 | F8 | F9 |
|---|---|---|---|---|---|---|---|---|---|
| Nystatin (mg) | 10 | 10 | 10 | 10 | 10 | 10 | 10 | 10 | 10 |
| Span 60 (mg) | 50 | 70 | 90 | 140 | 150 | 160 | 90 | 100 | 110 |
| Oleic acid (mg) | 5 | 10 | 20 | - | - | - | 5 | 10 | 15 |
| Stearic acid (mg) | - | - | - | 40 | 50 | 60 | 20 | 25 | 30 |
| Cholesterol (mg) | 30 | 40 | 50 | 50 | 60 | 70 | 60 | 60 | 60 |
| Ethanol: Phosphate buffer (mL) | 1:5 | 1:5 | 1:5 | 1:5 | 1:5 | 1:5 | 1:5 | 1:5 | 1:5 |
| Novasomal Suspension (mL) | 25 | 25 | 25 | 25 | 25 | 25 | 25 | 25 | 25 |
| Carbopol (g) | 20 | 20 | 20 | 20 | 20 | 20 | 20 | 20 | 20 |
| H2O (mL) | 50 | 50 | 50 | 50 | 50 | 50 | 50 | 50 | 50 |
| Nystatin-loaded novasomal gel (g) | 30 | 30 | 30 | 30 | 30 | 30 | 30 | 30 | 30 |
Disclaimer/Publisher’s Note: The statements, opinions and data contained in all publications are solely those of the individual author(s) and contributor(s) and not of MDPI and/or the editor(s). MDPI and/or the editor(s) disclaim responsibility for any injury to people or property resulting from any ideas, methods, instructions or products referred to in the content. |
© 2025 by the authors. Licensee MDPI, Basel, Switzerland. This article is an open access article distributed under the terms and conditions of the Creative Commons Attribution (CC BY) license (https://creativecommons.org/licenses/by/4.0/).
Share and Cite
Mustafa, M.A.; Fahad, M.; Mughal, M.; Rasheed, N.; Alqahtani, S.S.; Iqbal, M.Z. Development and Evaluation of Nystatin-Loaded Novasomal Gel for the Treatment of Candida albicans Infection: In Vitro Microbiological and Skin Compatibility Study. Gels 2025, 11, 774. https://doi.org/10.3390/gels11100774
Mustafa MA, Fahad M, Mughal M, Rasheed N, Alqahtani SS, Iqbal MZ. Development and Evaluation of Nystatin-Loaded Novasomal Gel for the Treatment of Candida albicans Infection: In Vitro Microbiological and Skin Compatibility Study. Gels. 2025; 11(10):774. https://doi.org/10.3390/gels11100774
Chicago/Turabian StyleMustafa, Muhammad Abid, Muhammad Fahad, Maryam Mughal, Namra Rasheed, Saad S. Alqahtani, and Muhammad Zahid Iqbal. 2025. "Development and Evaluation of Nystatin-Loaded Novasomal Gel for the Treatment of Candida albicans Infection: In Vitro Microbiological and Skin Compatibility Study" Gels 11, no. 10: 774. https://doi.org/10.3390/gels11100774
APA StyleMustafa, M. A., Fahad, M., Mughal, M., Rasheed, N., Alqahtani, S. S., & Iqbal, M. Z. (2025). Development and Evaluation of Nystatin-Loaded Novasomal Gel for the Treatment of Candida albicans Infection: In Vitro Microbiological and Skin Compatibility Study. Gels, 11(10), 774. https://doi.org/10.3390/gels11100774

